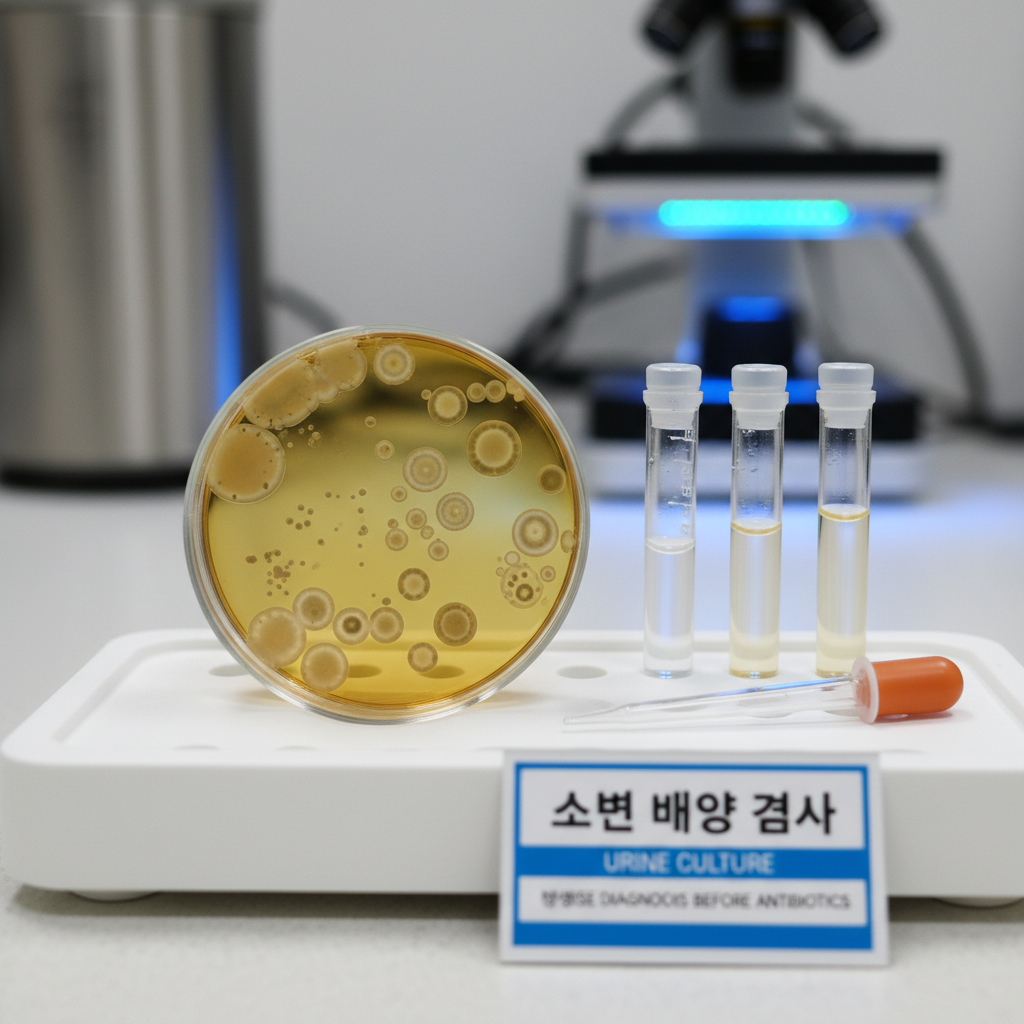

안녕하세요! 혹시 방광염 때문에 일상이 힘드신가요? 제 주변에도 이 문제로 고생하는 친구들이 꽤 많아서, 저 역시 이 질환에 대해 깊이 있게 찾아보게 되었는데요. 단순히 불편한 정도를 넘어, 삶의 질을 크게 떨어뜨릴 수 있는 방광염. 하지만 너무 걱정하지 마세요! 요즘은 다양한 치료법과 예방 전략이 잘 알려져 있어서, 꾸준히 관리하면 충분히 편안한 일상을 되찾을 수 있답니다.



저는 오늘, 방광염으로 힘들어하는 모든 분들을 위해, 최신 의학 정보를 바탕으로 효과적인 치료법과 실생활에서 적용할 수 있는 예방 수칙들을 꼼꼼하게 정리해봤어요. 단순히 약 복용에 그치지 않고, 우리 몸을 건강하게 지키는 전반적인 방법에 대해 함께 이야기해보려고 합니다. 자, 그럼 방광염에 대한 모든 궁금증을 풀어볼까요?
🚨 방광염, 왜 생기는 걸까요? (원인과 증상)
방광염은 쉽게 말해 방광에 염증이 생기는 질환이에요. 대부분의 경우 세균 감염이 주된 원인인데, 특히 여성에게서 훨씬 흔하게 발생하죠. 왜냐하면 여성의 요도 길이가 남성보다 짧고, 항문과 가까워서 세균이 방광으로 침투하기 더 쉬운 구조이기 때문이에요. 음… 제 생각엔 이런 구조적인 차이가 가장 큰 원인이라고 볼 수 있을 것 같아요.



물론 세균 감염 외에도 다양한 요인이 방광염을 유발할 수 있어요. 예를 들어, 소변을 너무 오래 참는 습관, 스트레스, 면역력 저하, 특정 약물 복용 등이 여기에 해당될 수 있습니다.
💡 방광염의 주요 증상은 다음과 같아요:
- 소변을 볼 때 느껴지는 따갑거나 아픈 통증 (배뇨통)
- 평소보다 소변을 자주 보게 되는 빈뇨 증상
- 갑자기 소변이 마려워 참기 힘든 절박뇨
- 하복부나 치골 부위의 불편함 또는 통증
- 소변에서 불쾌한 냄새가 나거나 탁하게 변하는 경우
- 심한 경우 혈뇨가 나타나기도 합니다.
이런 증상들이 나타난다면 빠르게 전문가의 도움을 받는 것이 중요해요.
🔬 방광염 진단, 어떻게 이루어지나요?
방광염 진단은 생각보다 간단해요. 병원에 방문하면 주로 소변 검사를 통해 염증 여부와 원인균을 확인하게 됩니다. 저도 예전에 친구가 방광염으로 병원에 갔을 때, 소변 검사만으로 바로 알 수 있었다고 하더라고요.
가장 기본적인 검사는 요검사(Urinalysis)인데, 이를 통해 소변 내 백혈구, 적혈구, 세균 유무 등을 파악할 수 있어요.



만약 세균 감염이 의심된다면, 소변 배양 검사(Urine Culture)를 실시해서 어떤 종류의 세균이 감염을 일으켰는지, 그리고 어떤 항생제에 잘 반응하는지를 정확히 알아낼 수 있습니다. 이 과정이 제대로 되어야 가장 효과적인 치료를 시작할 수 있겠죠?
💊 효과적인 방광염 치료법, 자세히 알아봐요!
1. 항생제 치료: 가장 기본적이고 강력한 방법
급성 방광염의 경우, 세균 감염이 대부분이기 때문에 항생제 치료가 가장 중요하고 효과적인 방법이에요. 의사 선생님이 처방해주시는 항생제를 복용하면, 보통 며칠 내로 증상이 빠르게 호전되는 것을 느낄 수 있을 거예요. 저도 이런 빠른 효과 때문에 초기에 잘 대처하는 것이 중요하다고 생각해요.
항생제의 종류와 복용 기간은 감염된 세균의 종류와 환자의 상태에 따라 달라지는데, 보통 3일에서 7일 정도 복용하게 됩니다. 물론 만성 방광염이나 재발성 방광염의 경우에는 좀 더 긴 기간 동안 치료가 필요할 수도 있어요.
⚠️ 절대 잊지 마세요! 증상이 좋아졌다고 해서 임의로 항생제 복용을 중단하면 안 돼요. 남은 세균들이 다시 증식해서 방광염이 재발하거나, 항생제 내성을 키울 수 있기 때문이죠. 의사가 지시한 기간 동안 끝까지 복용하는 것이 정말 중요합니다.

2. 비약물 치료 및 생활 습관 개선: 예방은 최고의 치료!
항생제 치료만큼이나 중요한 것이 바로 생활 습관 개선과 비약물 치료법이에요. 사실 이 부분이 방광염의 잦은 재발을 막는 데 결정적인 역할을 하죠. 제가 겪어본 바로는, 이런 사소해 보이는 습관들이 엄청난 차이를 만들더라고요!
| 구분 | 핵심 내용 |
|---|---|
| 수분 섭취 | 하루 1.5~2리터 이상의 물을 충분히 마셔서 소변으로 세균을 자주 배출하세요. |
| 올바른 배뇨 습관 | 소변이 마려우면 참지 말고 바로 화장실에 가고, 소변 볼 때는 방광을 완전히 비우도록 노력하세요. |
| 개인 위생 관리 | 배변 후 앞에서 뒤로 닦는 습관을 들이고, 통풍이 잘 되는 속옷을 착용하는 것이 좋습니다. |
| 크랜베리 섭취 | 크랜베리에 함유된 프로안토시아니딘(PACs) 성분이 세균이 방광 벽에 부착하는 것을 막아준다고 알려져 있어요. 주스나 보충제 형태로 섭취할 수 있습니다. |
| 성생활 후 관리 | 성관계 후에는 바로 소변을 보고, 물을 마셔서 방광 내 세균을 씻어내는 것이 도움이 됩니다. |



3. 재발 방지를 위한 장기적인 관리: 꾸준함이 답!
방광염은 한 번 앓고 나면 재발하기 쉬운 질환이라서 꾸준한 관리가 정말 중요해요. 저는 개인적으로 이 부분이 가장 어렵지만, 또 가장 핵심적이라고 생각해요.
- 면역력 강화: 충분한 휴식, 균형 잡힌 식단, 규칙적인 운동으로 전반적인 면역력을 높여주세요.
- 스트레스 관리: 스트레스는 면역력 저하의 주요 원인이 될 수 있으니, 자신만의 스트레스 해소법을 찾는 것이 좋아요.
- 주기적인 검진: 특히 재발이 잦다면, 정기적인 검진을 통해 방광 건강을 확인하고 초기 증상이 있을 때 바로 대처하는 것이 좋습니다.
📌 이럴 땐 즉시 병원으로!
- 고열, 오한, 옆구리 통증 등 신우신염(신장 감염)이 의심되는 증상이 나타날 때
- 항생제 복용 후 2~3일이 지나도 증상 호전이 없을 때
- 혈뇨가 심하거나 육안으로 확인될 때
이런 경우에는 합병증의 위험이 있으니 주저하지 말고 바로 의료기관을 찾아야 해요.



💡 핵심 요약
- ✔️ 방광염은 세균 감염이 주원인이며, 여성에게 더 흔해요. 소변 검사로 쉽게 진단할 수 있습니다.
- ✔️ 항생제 치료가 가장 효과적이지만, 임의 중단은 금물! 꼭 의사의 지시에 따라 완료해야 합니다.
- ✔️ 충분한 수분 섭취, 올바른 배뇨/위생 습관은 재발 방지에 필수예요. 크랜베리 섭취도 도움이 될 수 있습니다.
- ✔️ 면역력 강화와 스트레스 관리, 정기적인 검진으로 장기적인 방광 건강을 지키세요.
본 요약은 주요 정보만을 담고 있으므로, 자세한 내용은 본문을 참고해 주세요.
❓ 자주 묻는 질문 (FAQ)
Q1: 방광염은 꼭 병원에 가야 하나요? 자연 치유는 안 되나요?
A1: 가벼운 증상의 경우 자연 치유를 기대하기도 하지만, 세균 감염이 원인이므로 방치하면 신우신염과 같은 더 심각한 합병증으로 발전할 수 있어요. 전문가의 정확한 진단과 적절한 항생제 치료를 받는 것이 가장 안전하고 효과적입니다. 저는 빨리 병원에 가서 치료받는 게 현명하다고 봐요.
Q2: 크랜베리 주스가 방광염 예방에 정말 도움이 되나요?
A2: 네, 크랜베리에는 프로안토시아니딘(PACs)이라는 성분이 들어있는데, 이 성분이 요로 감염을 일으키는 세균이 방광 벽에 붙는 것을 억제하는 데 도움을 줄 수 있다고 알려져 있어요. 하지만 이미 발생한 방광염을 치료하는 약으로 생각하기보다는, 예방이나 재발 방지 보조 수단으로 활용하는 것이 좋습니다.
Q3: 방광염이 자주 재발하는데, 어떻게 해야 할까요?
A3: 재발성 방광염은 정말 힘들죠. 이런 경우엔 의료진과의 상담을 통해 정기적인 저용량 항생제 복용, 면역력 강화, 그리고 위생 및 생활 습관 전반에 대한 종합적인 관리가 필요해요. 정확한 원인을 찾아 맞춤형 해결책을 찾는 것이 중요합니다. 너무 혼자 힘들어하지 말고 꼭 전문가와 상의해 보세요!
오늘 이렇게 방광염의 원인부터 진단, 그리고 다양한 치료법과 예방, 관리 방법에 대해 자세히 알아보았어요. 방광염은 흔한 질환이지만, 적절한 관리와 관심으로 충분히 극복할 수 있답니다. 고통받고 있는 분들에게 제 글이 작은 위로와 희망이 되었으면 좋겠어요! 항상 건강하게, 활기찬 일상을 보내시길 진심으로 응원합니다!
본 포스팅은 정보 제공을 목적으로 작성되었으며, 전문적인 조언을 대체할 수 없습니다.
---
자료 출처: 대한비뇨의학회, 질병관리청, 건강보험심사평가원